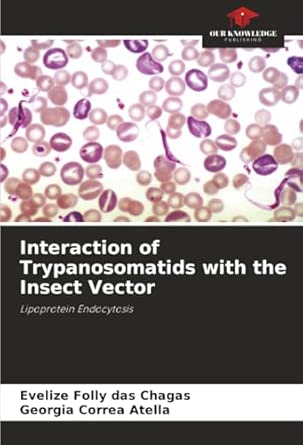
Interaction Of Trypanosomatids With The Insect Vector Lipoprotein Endocytosis

![]()
Back to School Deal
Get 50% OFF
Study Help!
--h --m --s
Claim Now
![]()
![]()